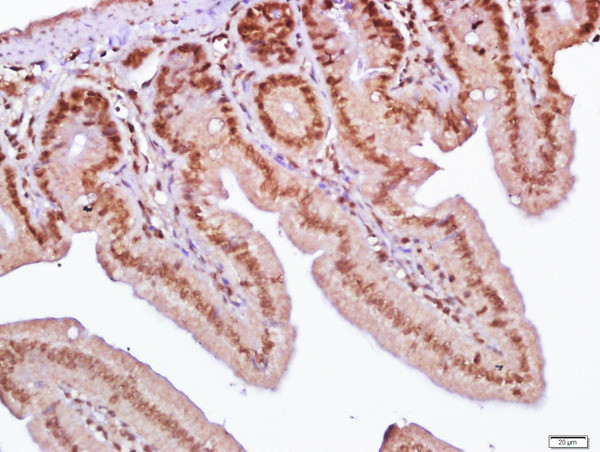
SLC38A2/SNAT2 Antibody in Immunohistochemistry (Paraffin) (IHC (P))

Search
Bioss
SLC38A2/SNAT2 Polyclonal Antibody
{{$productOrderCtrl.translations['antibody.pdp.commerceCard.promotion.promotions']}}
{{$productOrderCtrl.translations['antibody.pdp.commerceCard.promotion.viewpromo']}}
{{$productOrderCtrl.translations['antibody.pdp.commerceCard.promotion.promocode']}}: {{promo.promoCode}} {{promo.promoTitle}} {{promo.promoDescription}}. {{$productOrderCtrl.translations['antibody.pdp.commerceCard.promotion.learnmore']}}
图: 1 / 2
SLC38A2/SNAT2 Antibody (BS-12125R) in IHC (P)


产品信息
BS-12125R
种属反应
宿主/亚型
分类
类型
抗原
偶联物
形式
浓度
规格
纯化类型
保存液
内含物
保存条件
运输条件
靶标信息
Under hypertonic conditions the induction of SLC38A2/SNAT2 leads to the stimulation of transport system A and to the increase in the cell content of amino acids. Its amino acid response element, along with a nearby conserved CAAT box, has enhancer activity in that it functions in an orientation and position independent manner, and it confers regulated transcription to a heterologous promoter.
仅用于科研。不用于诊断过程。未经明确授权不得转售。
篇参考文献 (0)
生物信息学
蛋白别名: amino acid system A transporter; amino acid transporter 2; Amino acid transporter A2; amino acid transporter cationic 2; amino acid transporter system A2; amino acid transporter, cationic 2 (low affinity); ATA2; predicted protein of HQ1068; Protein 40-9-1; SLC38A2; Sodium-coupled neutral amino acid symporter 2; sodium-coupled neutral amino acid transporter 2; Solute carrier family 38 member 2; System A amino acid transporter 2; System A transporter 1; System N amino acid transporter 2; unnamed protein product
基因别名: 5033402L14Rik; AI316867; ATA2; Atrc2; KIAA1382; mKIAA1382; PRO1068; Sa1; SAT2; SLC38A2; SNAT2
UniProt ID: (Human) Q96QD8, (Rat) Q9JHE5, (Mouse) Q8CFE6
Entrez Gene ID: (Human) 54407, (Rat) 29642, (Mouse) 67760